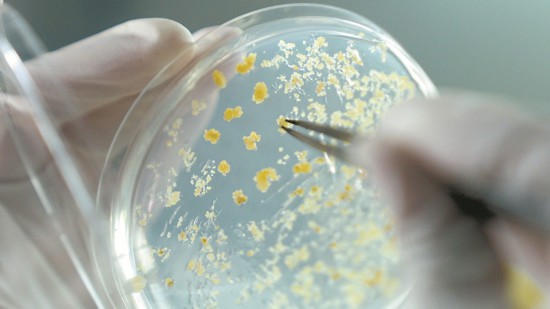

种业作为农业产业链的源头,是国家粮食安全和农业持续发展的基础。
种子之于农业,犹如芯片之于科技发展。作为一个农业大市,徐州的粮食产量和种子质量对于淮海经济区,乃至整个中国都发挥着至关重要的作用。徐州如何做强“农业芯片”?近年来,徐州始终牢记扛稳国家粮食安全政治责任,抓好种子农业“芯片”,强化科技支撑,不断夯实粮食丰产丰收的基础。
数据显示,“十三五”以来,徐州相继育成优良农作物新品种44个,17个品种连续多年入选江苏省、徐州市和宿迁市主推品种,33个品种实现转让,为农业产业提档升级、农民增收、农业增效提供了有力支撑。

端稳“饭碗”
徐州贡献一己之力
2022年1月的丰县,60多万亩小麦长出绿油油的叶子,一望无际,在广阔的田野“绘就”希望的绿色……而这,得益于一场种业发展的“翻身仗”。
小麦是世界上最重要的农作物之一。但因为小麦是异源六倍体,基因组庞大且复杂,因此对小麦的研究也最为困难。其中被称为小麦“癌症”的赤霉病严重威胁粮食生产和食品安全,仅仅依靠药剂预防也不是最佳的解决办法。
这样的背景下,徐州的小麦育种专家们从长江中下游麦区引进优异抗赤霉病、抗白粉病种质资源,综合利用分子标记技术和人工接种鉴定,培育出了适合本地种植的一系列中抗(或中感)赤霉病、白粉病免疫(高抗)的白皮小麦新种质,着实打赢了一场种子改良的硬仗。

“经过近几年的攻关,育成中抗赤霉病的小麦新品种徐农029,被农业农村部评为绿色品种。”国家小麦产业技术体系徐州综合试验站站长冯国华介绍。
在徐州,提到良种,大家就会想到一个人,他就是长期从事甘薯新品种选育工作的马代夫。
40多年来,马代夫带领团队潜心研究,在国内首创甘薯骨干亲本研究和利用技术,育成甘薯新品种59个,还倡导研制甘薯病毒检测和脱毒薯培育利用技术,累计推广面积1.3亿亩,成为甘薯产业发展史创举。
徐州是种植业需种用种大市,也是种子、种苗生产供应大市。徐麦系列种植面积每年在500万亩以上;水稻在江苏、安徽、山东、河南等地种植面积每年在100万亩左右;大豆在黄淮地区种植面积每年大概10万亩,湖北省每年种植60万亩;花生在徐州、连云港、河南、安徽等省年种植面积约50万亩;徐紫薯8号、徐薯37等每年种植面积90万亩……
徐州现有农作物种子生产经营持证企业21家,农作物种子经营门店1400家。优势特色种苗基地近50个,认定为江苏省优势特色种苗中心的有20家。全市稻麦繁殖田15万亩,杂交制种面积1万亩,辣椒制种基地1.5万亩,其中沛县获批第二批国家区域性良种繁殖基地,辣椒制种量占全国的30%左右,辣椒种子产值近3亿元。
一组组亮眼数字的背后,是徐州几代育种科研人员的努力,也是徐州种业成功逆袭的生动阐释。
守好“芯片”
育种产业亟待突破
徐州虽然是用种供种大市,但农科院专家表示,徐州种业市场受河南、安徽、山东和本省的种子企业冲击影响很大,种子核心竞争力低、市场竞争力弱,并且外来种子在土壤适配度上不是完全合适的。
“面对徐州种业市场品种多且杂的问题,提高徐州种源自给率刻不容缓,这需要在资源收集、科研力量、技术应用等方面狠下功夫。”徐州市农业科学院副院长杨峰表示。
针对短板问题,科研一线正在抓紧“破卡”。
实验室内,科研人员正在抓紧整理种子相关试验数据,挑选分装种子以备接续试验。实验室外,在徐州经开区大庙街道的徐州现代农业实验示范基地里,育种专家正开展试验苗情、病虫情田间调查。
如果说,科研人员争分夺秒想尽快拿到一个理想品种来推广是提高徐州种子市场竞争力的有力举措,那么全面育种创新攻关更是刻不容缓。
采访中,农科院有关专家和种业企业表示,打赢种业翻身仗还必须解决几个关键问题:
——经费保障难度大。种质资源保护是一项基础性、长期性的公益性工作,周期长、成本高,需要持续的经费投入,目前经费不足,难以保障系统性的种质资源保护工作。
——保护平台缺乏。目前,徐州种质资源保护的基础设施和保存手段还不够完善,容易造成种质资源损失。“我们将加强种质资源保护利用和种子库建设,确保种源安全。”马代夫说。
——种业企业的资源保护和创新不足。种业企业在资源保护、挖掘利用等方面投入不足,严重制约了种质资源保存和优异资源创制,造成育成品种与科研单位的同质化现象严重。

科技创新
打赢种业翻身仗
种业如何打赢翻身仗?中央一号文件提出,要加强农业种质资源保护开发利用。
徐州农科院甘薯育种研究室副研究员后猛告诉记者,“每一种种质资源都蕴含着丰富的遗传多样性,优异的基因越多,越有可能结合出优质的种子,尤其体现在抗病性上。”
后猛介绍,以徐州甘薯为例,为保护好甘薯种质资源,建成了国内保存种类和数量最多、遗传多样性最丰富的甘薯种质试管苗保存库和田间资源保存圃,保存的种质类型已扩增到10个,保存资源数量超过1200份,其中通过鉴定评价创新种质材料20余份。
“我们现保存小麦、水稻、甘薯、棉花、大豆、花生、大蒜、苹果、草莓、山药、马铃薯等各类种质资源7949份。”杨峰说。
7949这个数字不仅保证了种质资源的丰富性,也为下一步的种子研发奠定了良好的基础。
杨峰介绍,徐州还在努力建设各类种质资源保存库、保存圃,为种质资源的保护和利用提供重要基础保障。
近几年,徐州先后建设了江苏省徐淮地区国家农作物品种区域试验站、国家甘薯种质徐州试管苗库、农业农村部甘薯生物学与遗传育种重点实验室、国家甘薯产业技术研发中心、国家土壤质量徐州观测实验站等18个部省级平台。
与科研单位和高校合作有助于刺激创新,是提升徐州育种效率、加强育种水平的重要一环。“这几年,与科研院所、高校合作,加强表型鉴定、分子设计育种、基因编辑等生物育种技术的研发和应用,切实为我市提高现代农业水平和产业集群提供了技术支撑。”杨峰表示。
正如杨峰所说,在一系列举措的支撑下,徐州种业得到了跨越式发展,各项数据不断刷新:筛选出高抗稻瘟病的种质资源3份,选育出优良水稻品种13个;利用转基因抗虫棉材料,先后育成徐棉21号、徐棉266等6个棉花新品种;培育通过省级以上审定的大豆新品种20余个;培育20余个花生新品种;累计向全国115家单位有效提供利用资源2188份次,支撑培育甘薯新品种75个。
种业是粮食之基,打赢种业“翻身仗”,对于保障粮食安全意义重大。“一方面我们希望政府加大种业研发投入,重点支持产学研深度合作,提高种子产业整体水平。另一方面支持鼓励企业牵头承担育种工程项目,通过协作攻关,加快培育核心竞争力的产业主体。”杨峰建议。






公安备案号:32010202010067